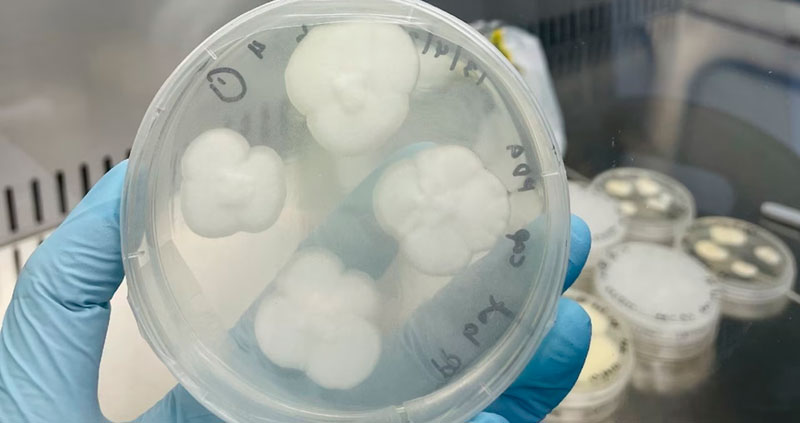

Logran degradar uno de los plásticos más resistentes usando hongos comunes
Científicos de la Universidad de Sídney han degradado con éxito, usando dos cepas de hongos comunes, uno de los plásticos más difícil de reciclar, el polipropileno, que representa el 28% de los residuos de este tipo a nivel mundial.
Un experimento de laboratorio demostró que los hongos ‘Aspergillus terreus’ y ‘Engyodontium album’, que normalmente se encuentran en el suelo y las plantas, lograron descomponer diferentes productos fabricados a base de polipropileno (película metalizada, gránulos y polipropileno flexible), después de haberlos tratado previamente con luz ultravioleta, calor o reactivo de Fenton, según el estudio publicado en la revista científica npj Materials Degradation el pasado viernes.
Sorprendentemente, se develó que estos organismos redujeron el polímero en un 21% durante 30 días y hasta un 25-27% tras más de 90 días. Estos resultados han impulsado a los expertos australianos a investigar más a fondo el papel de los procesos biológicos que ofrecen los hongos y otros organismos para acelerar la degradación de los plásticos.
«El polipropileno es un plástico común que se usa para fabricar una gran variedad de productos de uso diario, como recipientes para alimentos, perchas y film de plástico, pero solo tiene una tasa de reciclaje del 1%», dijo la autora principal del estudio, Amira Farzana Samat, y sostuvo que esta baja tasa contribuye a la acumulación excesiva de este tipo de residuos y a la contaminación ambiental.
Los científicos aseguran que este polímero se recicla con poca frecuencia debido a su corta vida como material de empaque y, además, habitualmente se contamina con otros materiales, lo que requiere desarrollar nuevos métodos de reciclaje que tengan un mínimo impacto ambiental.
‘Superpoder’ en la lucha contra los residuos plásticos
Según Samat, se estima que se han acumulado 109 millones de toneladas de residuos plásticos en los ríos del mundo y 30 millones de toneladas en los océanos, y las fuentes pronostican que esta colosal cantidad pronto superará la masa total de peces. En ese contexto, los investigadores creen que su método podría ayudar a reducir la gran cantidad de plástico que contamina el medioambiente, ya que los hongos pueden descomponer casi cualquier tipo de sustancia.
«Este superpoder se debe a su producción de poderosas enzimas, que se excretan y se utilizan para descomponer los sustratos en moléculas más simples que las células fúngicas puedan después absorber», explicó otro de los autores de la investigación, el profesor Dee Carter, experto en micología. Con RT
